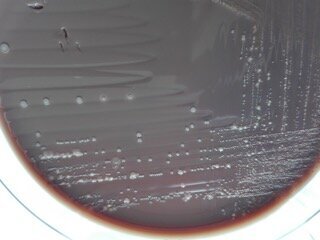
Ryc. 1_Hodowle bakterii, widoczne liczne kolonie bakteryjne

Zabiegi chirurgiczne związane z augmentacją czy sterowaną regeneracją kości są coraz częściej wykonywane przez lekarzy dentystów. Pomimo znacznego postępu i mnogości materiałów do GBR, wciąż za najlepszy uważa się materiał autogenny, zawiera on bowiem żywe komórki kostne i białka indukujące osteogenezę. Chęć zastosowania materiału autogennego do GBR czy socket preservation wymagała do tej pory dodatkowego zabiegu w postaci pobrania tkanki z miejsca innego niż operowane, czyli miejsca biorczego.
Najlepszą okolicą w jamie ustnej do pozyskania tego materiału jest okolica bródkowa i trójkąt zatrzonowcowy. Procedura ta poza tym, że wymaga sporych umiejętności od operatora, budzi także obawy i niechęć wśród pacjentów związaną z kolejną raną w jamie ustnej. W związku z tym postanowiono spróbować powrócić do badań i koncepcji związanej z wykorzystaniem usuniętych zębów jako materiału autogennego do regeneracji ubytków kostnych. Na rynku lobbowana jest metoda mielenia usuniętych zębów poprzedzona ich „dekontaminacją”, a następnie wykorzystaniem ich jako materiał do GBR. Wyżej wymieniona koncepcja zaczęła dzielić środowisko lekarskie na zwolenników i przeciwników, widzących potencjalne zagrożenie dla pacjenta ze strony zmielonych zębów. Autorzy poddali analizie i dogłębnie zbadali tego typu materiał autogenny. Ze zmielonych zębów zatrzymanych oraz usuniętych w wyniku sanacji pobrano próbki i wykonano posiewy. Wyniki opracowano w formie wykresów kołowych. Wyhodowano bakterie z grupy Staphylococus, Streptococcus, Enterococus, Bacillus itd., wśród których wyodrębniono liczne bakterie chorobotwórcze i patogenne. Analiza wyników skłania do refleksji i dalszych badań nad modyfikacją procedury przygotowania i dekontaminacji zmielonych zębów.
Najefektywniejszą procedurą w sterowanej regeneracji kości (GBR) jest zastosowanie tzw. złotego standardu – przeszczepienia autogennej, żywej tkanki kostnej z miejsc ortotopowych w jamie ustnej (okolica bródkowa kości żuchwy, trójkąt zatrzonowcowy, gałąź żuchwy oraz rzadziej – ektopowych (np. fragment grzbietu talerza kości biodrowej, kość strzałki, sklepienie czaszki). Kość autogenna zawiera, poza żywymi komórkami kostnymi, ok. 1% organicznych składników w postaci białek morfogenetycznych kości (BMP), niezbędnych w osteogenezie.
Zdolności osteogenne tkanek zminealizowanych, zdewitalizowanych, np. przeszczepy allogeniczne kości zawierają śladowe stężenia tych białek i wykazują efekt osteoindukcji z ograniczoną osteogenezą. Przeszczep allogeniczny kości ulega stopniowej resorpcji i zastępowaniu przez nowopowstającą tkankę kostną biorcy, jednak ze znacznym obniżeniem objętości.
W latach 40. ubiegłego stulecia dr Marshal Urist, Huggins, następnie Obersztyn, Ostrowski, Komender, Gocławska, Włodarski i Wojtowicz wykazali w badaniach na zwierzętach możliwości tzw. osteogenezy heterotopowej, stosując wiele modeli doświadczalnych. Wykazali jednocześnie, iż warunkiem tej osteogenezy w tkankach niezmineralizowanych są białka morfogenetyczne kości (BMPs). Prof. Obersztyn prowadził badania nad obecnością BMPs i innych morfogenów w zębinie, był pionierem badań nad zdolnościami osteogennymi przeszczepionej, procesowanej zębiny, która nie tworzy de novo zębiny, lecz ogniska tkanki kostnej. Badania te prowadzone były również na modelu zwierzęcym.
Zdolności osteogenne zębiny były wielokrotnie później badane pod kątem wykorzystania u ludzi w regeneracji tkanki kostnej. Metodologia ta powróciła w ubiegłych latach. Podjęto próbę standaryzacji przygotowania autogennej masy złożonej ze szkliwa, zębiny oraz cementu, nazwaną „metodą pozyskiwania zębiny autogennej”. Wielu autorów podkreśla wątpliwości metodologiczne wynikające z kontaminacji tkanek zęba mielonego bakteriami. Autorzy metody i klinicyści stosujący te procedury z jednej strony podkreślają, iż usuwane zęby ze wskazań, zwykle konsekwencji zakażeń bakteryjnych, z drugiej strony, ich zdaniem zęby usuwane ze wskazań ortodontycznych oraz zatrzymane zęby mądrości są „czyste bakteriologicznie” i stanowią doskonałe, dostępne i tanie źródło materiału do augmentacji.
W celu dekontaminacji stosują i rekomendują oni inkubację rozdrobnionego zęba w: 0,5M NaOH, 20% etanolu oraz buforowany roztwór soli fizjologicznej do odpłukania wodorotlenku sodowego i alkoholu. Procedury te w założeniu odbywają się w czasie określonym na 20 min między usunięciem zęba a jego wszczepieniem po procesowaniu przy fotelu pacjenta. Metodologia prof. Bindermana, jednego z twórców metody nie zawiera żadnej formy kontroli mikrobiologicznej i standaryzacji pozyskiwanego przeszczepu.
Autorzy niniejszej pracy podjęli badania mikrobiologiczne pozyskanego przeszczepu zębów usuniętych z powodu konsekwencji próchnicy (martwica/zgorzel miazgi – wskazania do sanacji), tzw. „hopeless tooth”, a także całkowicie zatrzymanych 3. zębów mądrości.
Stany zapalne tkanek okołozębowych, zakażenia okołowierzchołkowe zębów oraz bakteryjne zapalnie miazgi wywoływane są przez liczne mikroorganizmy. Zakażenia te zwykle mają charakter mieszany, tj. wywołane są przez bakterie bezwzględnie beztlenowe, np. Prevotella spp., Fusobacterium spp., fakultatywne beztlenowce, np. paciorkowce z grupy zieleniących (Streptococcusviridans group) lub z grupy S. anginosus. Udział w tych zakażeniach mogą mieć również bakterie tlenowe, stanowiące florę fizjologiczną jamy ustnej, lecz zdolne do wywołania zakażeń oportunistycznych, np. gronkowce koagulazoujemne (coagulase nagative Staphylococcus).
Materiały i metody
Pozyskanie materiału badawczego
Materiał do badań stanowiły zęby pozyskane w wyniku ekstrakcji przeprowadzonych w Zakładzie Chirurgii Stomatologicznej Warszawskiego Uniwersytetu Medycznego. Próbki podzielono na 2 grupy. Grupa 1 (O) to całkowicie zatrzymane zęby 3. trzonowe usuwane ze względów ortodontycznych u pacjentów bez jakichkolwiek objawów klinicznych i radiologicznych ostrego lub przewlekłego procesu zapalnego. Liczebność tej grupy wynosiła n = 15. Grupa 2 (Z) to zęby usuwane z różnych wskazań w związku z brakiem możliwości dalszego leczenia zachowawczego. Zębom tym mogły towarzyszyć przewlekłe lub ostre stany zapalne zębopochodne. Wykluczone były zęby uprzednio leczone endodontycznie i w związku z tym posiadające jakiekolwiek materiały wypełniające lub lecznicze w systemie komorowo-korzeniowym. Liczebność w tej grupie wynosiła n = 20.
Przygotowanie próbek
Każdy ząb był traktowany jako osobna próbka i nie miał styczności z inną próbką. Wszystkie próbki były preparowane bezpośrednio po ekstrakcji z zachowaniem zasad aseptyki. W pierwszym etapie przepłukiwano je roztworem soli fizjologicznej i oczyszczano ostrymi kiretami z resztek ozębnej. W grupie 2 wszelkie ślady próchnicy czy materiału wypełniających były usuwane za pomocą wierteł z nasypem diamentowym osadzonych na końcówkę turbinową. Po mechanicznym oczyszczeniu próbki ponownie były płukane roztworem soli fizjologicznej, a następnie suszone sprężonym powietrzem.
Tak przygotowywany materiał był każdorazowo wkładany do komory mielącej urządzenia Smart Dentin Grinder KometaBio (USA). Proces mielenia i sortowania materiału biologicznego przeprowadzano zgodnie ze wskazaniami producenta urządzenia. Pozyskamy materiał odsypywano do dedykowanego sterylnego pojemniczka i zalewano na 10 min załączonym w zestawie roztworem Dentin Cleanser Kometa Bio (USA) tak, aby nawilżyć i pokryć cały materiał powstały z mielenia i sortowania zęba. Po 10 min nadmiar roztworu odsączano za pomocą sterylnych gazików.
W kolejnym etapie próbkę zalewano na 3 min dedykowanym roztworem Dulbecco’s Phosphate Buffered Saline KometaBio (USA). Następnie, nadmiar płynu absorbowano za pomocą sterylnych gazików. Całkowity czas od ekstrakcji do przygotowania próbki nie przekraczał 15-20 min. Próbki bezpośrednio po przygotowaniu były w całości przenoszone do uprzednio przygotowanego podłoża hodowlanego i odsyłane celem badania mikrobiologicznego.
Uzyskany w wyniku „mielenia” (mechanicznej homogenizacji) i opisanego powyżej procesowania w celu autotransplantacji, zgodnie z protokołem prof. Bindermana materiał przenoszono do 10 ml pożywki płynnej Schadler, inkubację prowadzono do 5 dni w temperaturze 37° C. Wzrost w hodowlach monitorowano co 24 godz. Z próbek, w których stwierdzono wzrost mikroorganizmów wykonywano przesiew na pożywki stałe dla bakterii tlenowych i beztlenowych, odpowiednio: Columbia agar z dodatkiem 5% erytrocytów baranich oraz Schedler agar z dodatkiem 5% erytrocytów baranich. Wyhodowane mikroorganizmy identyfikowano z wykorzystaniem spektrometrii mas połączonej z jonizacją próbki poprzez desorpcję laserem z matrycy i pomiarem czasu przelotu jonów (MALDI-TOF MS – matrix assisted laser desporption ionisation – time of flight mass spectrometry) na aparacie Vitek MS (bioMérieux) zgodnie z instrukcją producenta.
Wyniki
Z posiewów próbek pochodzących z zębów zatrzymanych (grupa „O”) uzyskano wzrost we wszystkich (n = 15) posiewach. Z próbek pochodzących z zębów w stanie zgorzelinowego rozpadu miazgi (n=20) – grupa „Z” uzyskano wzrost bakterii w 95% badanych próbek. W obu grupach uzyskano wzrost bakterii tlenowych i beztlenowych. Tylko 5% preparatów mielonych zębów przygotowanych w celu autotransplantacji, można było uznać za czyste mikrobiologicznie. Ocena ilościowa mikroorganizmów nie była przeprowadzona jako zbędna, skoro miano bakterii wystarczyło do ich wzrostu w warunkach in vitro, zbliżonych do tkankowych.
Występowanie bakterii (ocena jakościowa) w grupach „O” i „Z” przedstawiono na wykresach 1a i 1b. W grupie „O”, zębów zatrzymanych wyhodowano 22 szczepy bakterii, należące do 9 gatunków. Bakterie te należały do rodzajów: Bacillus, Corynebacterium, Lactobacillus, Paenibacillus, Staphylococcus, Streptococcus.
Na szczególną uwagę, zasługuje wyhodowanie w tej grupie bakterii z gatunku Bacillus cereus. Mikroorganizm ten odpowiedzialny jest głównie za zatrucia pokarmowe, ale jego udział w wywoływaniu zakażeń poza układem pokarmowym jest dobrze udokumentowany w literaturze medycznej. Patogenność laseczki B. cereus wynika głównie ze zdolności do wywarzania licznych egzotoksyn, wśród których znajdują się 4 hemolizyny, 3 fosfolipazy oraz proteazy. Ponadto, gatunek ten wytwarza beta-laktamazy, co sprawia, że w leczeniu empirycznym lekami z wyboru są: ciprofloksacyna lub wankomycyna podawana parenteralnie (Edward J. Bottone E. J. Bacillus cereus, a Volatile Human Pathogen.Clin Microbiol Rev. 2010 Apr; 23(2): 382–398.doi: 10.1128/CMR.00073-09).
W grupie „Z”, przeszczepu z mielonych zębów usuniętych ze wskazań następstw próchnicy – martwicy miazgi wyhodowano 42 szczepy bakterii należące do 17 gatunków. Bakterie te należały do rodzajów: Streptococcus, Staphylococcus, Lactobacillus, Enterococcus, Bifidobacterium, Bacillus oraz Clostridium. W obrębie paciorkowców (Streptococcus) zidentyfikowane gatunki należały do grup: S. salivarius group, S. anginosus group, S. mitis group oraz S. sangiunis group. Gatunki należące do wymienionych grup wchodzą w skład naturalnej, prawidłowej mikroflory jamy ustnej, jednakże u pacjentów z niedoborami odporności lub masywnej translokacji tych bakterii do układu krwionośnego mogą wywoływać zakażenia takie, jak: ropnie mózgu, ropnie w obrębie jamy ustnej, ropnie otrzewnej, infekcyjne zapalenie wsierdzia, posocznicę u pacjentów z neutropenią, zapalenie płuc, zapalenie opon mózgowo-rdzeniowych, bakteriemie.
Wśród mikroorganizmów wyhodowanych w grupie „Z” największym potencjałem chorobotwórczym charakteryzuje się Clostridium perfringens. Bakteria ta jest przetrwalnikującą Gram-dodatnią laseczką, za której patogenność odpowiada kilkanaście toksyn i enzymów. Najważniejsza z nich to toksyna alfa – lecytynaza (fosfolipaza C), która doprowadza do lizy erytrocytów, płytek krwi, leukocytów i komórek śródbłonka. W przebiegu zakażenia tkanek miękkich dochodzić może do zapalenia tkanki łącznej, zapalenia powięzi i ropiejącego zapalenia mięśni, martwicy mięśni i zgorzeli gazowej. Zakażenie ma bardzo szybki przebieg, który może doprowadzić do zgonu chorego w ciągu kilku dni.
Bakterie z rodzaju Enterococcus, choć nie posiadają dużych zdolności chorobotwórczych wynikających bezpośrednio z obecności czynników zjadliwości, mogą wywoływać poważne zakażenia. Szczepy z rodzaju Enterococcus wykazują naturalną oporność na wiele klinicznie istotnych antybiotyków, np. cefalosporyny, niskie stężania aminoglikozydów (gentamycyna, streptomycyna), linkozamidy (linkomycyna, klindamycyna), trimetoprim/sulfametoksazol, a także oporność nabytą, np. na glikopeptydy (wankomycyna, teikoplanina).
Udział bakterii z rodzaju Enterococcus w zakażeniach tkanek zęba jest dobrze udokumentowany. Występowanie bakterii z tego rodzaju, w szczególności należących do gatunku E. faecalis, stwierdzano w kanałach zębowych zarówno przed, jak i po zakończonym leczeniu endodontycznym. Bakteria ta może rezydować/wegetować zarówno w kanałach zębowych, jak i w otaczającej ząb tkance kostnej po ekstrakcji zęba. Prowadzić to może do kolonizacji implantu zębowego, a także do utraty żywotności kości i/lub jej ubytków.
W procesie kolonizacji zwykle uczestniczą również inne mikroorganizmy, wśród których E. faecalis nie jest dominującym gatunkiem, jednakże obecnie uważa się, że mogę on odgrywać kluczową rolę w tym procesie (Flanagan D. Enterococcus faecalis and Dental Implants. J Oral Implantol. 2017 Feb;43(1):8-11. doi: 10.1563/aaid-joi-D-16-00069. Epub 2016 Oct 4).
Bakterie z rodzaju Staphylococcus, gatunki koagulazo-ujemne, takie jak np. S. epidermidis są przyczyną zakażeń oportunistycznych, związanych głównie z wprowadzeniem do naczyń krwionośnych cewników lub wszczepieniem biomateriałów – sztuczne zastawki serca, endopotezy stawowe. Związane jest to z ich zdolnością do tworzenia struktury biofilmu, który chroni bakterie przed antybiotykami, a także przed komórkami odpowiedzi immunologicznej. W przebiegu tych zakażeń zwykle dochodzi do bakteriemii. Wśród gronkowców koagulazo-ujemnych bardzo często identyfikowane są szczepy metylinooporne (MRCNS), co oznacza, że szczepy takie są oporne na wszystkie antybiotyki beta-laktamowe bez i z inhibitorami beta-laktamaz, cefalosporyny oraz karbapenemy, z wyjątkiem tych antybiotyków, które są przeznaczone do leczenia zakażeń wywołanych przez szczepy metycylinooporne. Szczepy MRCNS niejednokrotnie są oporne także na antybiotyki z innych grup, co w konsekwencji prowadzi do ograniczenia wyboru antybiotykoterapii tylko do glikopeptydów, np. wankomycyny, podawanych parenteralnie w warunkach lecznictwa zamkniętego.
Dyskusja
Wyniki prowadzonych jakościowych badań mikrobiologicznych wykazują obecność kilkudziesięciu szczepów patogennych bakterii w materiale procesowanym zgodnie z zaproponowaną procedurą (Kim and Kim 2010, Bindermann). Obecność tych patogennych bakterii aerobowych w tkankach zęba, na jego powierzchniach, wewnątrz jamy zęba, w kanalikach zębinowych, w imperfekcjach szkliwa zwykle nie jest niczym szczególnym, ponieważ istnieją bariery przeciwdziałające zakażeniu. Taką barierę stanowią tkanki, komórki, grudki chłonne otaczające ząb, obecne w przestrzeni ozębnowej oraz w tkance łącznej dziąseł. Ząb jest usuwany wyłącznie ze wskazań, najczęściej w konsekwencji zakażeń tkanek zęba (próchnica, martwica/zgorzel miazgi, periimplantitis, ale także ze wskazań innych, np. ortodontycznych, jako ząb „zdrowy”, jednak nie wolny od bakterii. Zastosowana procedura poprzedzająca mielenie zęba, polegająca na oczyszczeniu mechanicznym powierzchni usuniętego zęba musi być precyzyjna i przez to jest żmudna, mielenie zęba zdecydowanie efektywne w młynku konstrukcji KometaBio.
W badaniach doświadczalnych prowadzonych w ubiegłym stuleciu (Marshall, Obersztyn, Ostrowski, Komender, Dziedzic-Gocławska, Wojtowicz) mielenie zębów prowadzone było w środowisku ciekłego azotu w celu zwiększenia kruchości mocno zmineralizowanych tkanek zęba. Ciekły azot (90o C) dodatkowo dekontaminował większość bakterii. Aczkolwiek ług sodowy jest czynnikiem chemicznym niszczącym priony, to zaproponowany roztwór wodorotlenku sodu posiada zdolności bakteriobójcze, a mimo to roztwór ten nie niszczy ich całkowicie. Roztwór alkoholu również posiada właściwości bakteriobójcze i dezynfekujące, lecz w tym stężeniu nie zabija wszystkich bakterii. Z kolei buforowana sól fizjologiczna (PBS) ma za zadanie odpłukać martwe bakterie, stanowi jednocześnie składnik pożywki do hodowli bakterii i komórek in vitro.
Stworzenie mikrobanku tkanek przy fotelu operowanego pacjenta nasuwa istotne i zrozumiałe wątpliwości natury formalnej. Tylko 5% przygotowanych przeszczepów wykazało w prowadzonych badaniach względną „czystość” mikrobiologiczną i ich zastosowanie nie budzi naszych wątpliwości, natomiast założenie pozostałych przeszczepów z jednej strony zwiększa ryzyko zakażenia kości (brak mechanizmów obronnych w kości), z drugiej – wymaga stosowania nieuzasadnionej farmakoterapii.
W naszych badaniach nie ocenialiśmy obecności beztlenowców. W świetle tysięcy publikacji wykazujących przeszczepy ksenogenne, alloplastyczne jako bezpieczne materiały do augmentacji, kilkanaście publikacji, znikoma liczba opisanych i udokumentowanych przypadków stosowania mielonych zębów jako przeszczepów autogennych jest zbyt mała, aby uznać metodologię przeszczepiania mielonych zębów jako wyższą od materiałów syntetycznych oraz pochodzenia zwierzęcego.
Poza wymienionymi wątpliwościami, zarówno koszt metody (młynka i jednorazowych wkładów) oraz czas ekstrakcji zęba i jego procesowania znacznie wydłuża zabieg chirurgiczny, podczas gdy preparaty dostępne komercyjnie wykazują podobny efekt, szczególnie gdy są wzbogacone preparatami krwiopochodnymi, np. fibryną bogatopłytową (A, iPRF i inne).
W świetle publikacji i wykonanych badań mikrobiologicznych należy stwierdzić, iż zaproponowana metoda posiada właściwe założenie, szczególnie, iż wiadomo o zdolnościach osteogennych zębiny. Zminimalizowanie procedur dekontaminujących, konserwujących i sterylizujących przeszczep autogennej, zdewitalizowanej zębiny, a więc procedur ustalonych dla bankowania tkanek skutkuje jednak nadal obecnością bakterii patogennych w przeszczepach i z tego powodu wymaga zmian w protokole przygotowania i postępowania z mielonymi zębami w celach augmentacji tkanki kostnej. Podobnie ograniczenie metodologii do procesowania żywych, mikrobiolgicznie czystych zatrzymanych całkowicie 3. zębów mądrości może uczynić tę metodę efektywną i bezpieczną.
Należy również rozważyć możliwość przygotowania przeszczepu autogennego mielonego zęba „na zamówienie” w banku tkanek, gdzie gwarantowane jest nie tylko bezpieczeństwo mikrobiologiczne, ale przeszczep może być przechowywany w formie mrożonej lub liofilizowanej przez dłuższy czas i być wykorzystany nawet do kilku zabiegów. Również z powodów kontaminacji mikrobiolgicznych, wzrostu flory bakteryjnej i procesów gnilnych nie powinniśmy rekomendować pacjentom przechowywania przez nich i kolekcjonowania zębów w warunkach domowych.
Autorzy:
Andrzej Wojtowicz, Piotr Wychowański, Martyna Osiak i Igor Kresa
Zakład Chirurgii Stomatologicznej WUM,
Zakład Mikrobiologii WUM
Robert Kuthan
Katedra i Zakład Mikrobiologii Lekarskiej
Warszawski Uniwersytet Medyczny WUM
Kierownik Katedry i Zakładu Mikrobiologii WUM
– prof. dr hab. n. med. Grażyna Młynarczyk
Piśmiennictwo:
- Edward J, Bottone EJ. Bacillus cereus, a Volatile Human Pathogen. Clin Microbiol Rev. 2010; 23(2): 382-398.
- Flanagan D. Enterococcus faecalis and Dental Implants. J Oral Implantol. 2017; 43(1):8-11.
- Kierzkowska M, Majewska A, Kuthan RT, Sawicka-Grzelak A, Młynarczyk G. A comparison of Api 20A vs MALDI-TOF MS for routine identification of clinically significant anaerobic bacterial strains to the species level. J Microbiol Methods. 2013; 92(2):209-12.
Ryc. 1_Hodowle bakterii, widoczne liczne kolonie bakteryjne
Ryc. 1_Hodowle bakterii, widoczne liczne kolonie bakteryjne
Wykres 1a_Posiew wykonany po zmieleniu zębów zatrzymanych. Widoczna przewaga bakterii z grupy paciorkowców. Na uwagę zasługuję także wysoki odsetek 9,1% gronkowców.
Wykres 1b_Posiew wykonany po zmieleniu zębów uzyskanych podczas sanacji jamy ustnej. W odniesieniu do materiały uzyskanego z zębów zatrzymanych wyhodowano patogenne szczepy z grupy Enterococcus i Clostridium.
Tagi:
INDIANAPOLIS, USA: Chociaż przeprowadzono wiele badań dotyczących przeżywalności zębów leczonych endodontycznie, tylko stosunkowo niewielka ich ...
W artykule przedstawiono wyniki badań kontaktu implantu tytanowego z kością po autotransplantacji osteointegrowanych implantów przy zastosowaniu ...
Przydatność komórek macierzystych w regeneracji tkanek zęba i innych tkanek potwierdza się w licznych badaniach, choć ich potencjał w warunkach ...
Dym papierosowy zawiera drobnoustroje i toksyny drobnoustrojowe, np. endotoksyny i glukan, które mogą mieć niekorzystny wpływ na układ oddechowy. W ...
Triada Regeneracyjna obejmuje m.in. molekuły sygnalizujące uwalniane z płytek krwi podczas urazu, zwane także czynnikami wzrostu. Miejscowe zwiększanie...
Triada Regeneracyjna obejmuje m.in. molekuły sygnalizujące uwalniane z płytek krwi podczas urazu, zwane także czynnikami wzrostu. Miejscowe zwiększanie...
Gojenie tkanek miękkich i kości po zabiegach chirurgicznych jest procesem wiążącym się często z licznymi komplikacjami oraz zakażeniami. Celem ...
Pacjent, który jest zadowolony ze swojego uśmiechu to pacjent lepiej współpracujący. Jedną z najprostszych i najskuteczniejszych metod ...
Kruszone lub sproszkowane skorupki jaj mają wiele praktycznych zastosowań. Można je stosować jako naturalny suplement wapnia, słodzik do kawy, lek na ...
Pacjenci cierpiący na nadwrażliwość zębów mają do dyspozycji szereg produktów pomagających im zwalczać objawy tej przypadłości, ...
Webinarium na żywo
czw. 4 czerwca 2026
8:00 (CET) Warsaw
Webinarium na żywo
pon. 8 czerwca 2026
6:00 (CET) Warsaw
Webinarium na żywo
pon. 8 czerwca 2026
7:00 (CET) Warsaw
Dr. Anthony Mak B.D.S, Prof. Marleen Peumans
Webinarium na żywo
pon. 8 czerwca 2026
8:00 (CET) Warsaw
Webinarium na żywo
śro. 10 czerwca 2026
5:00 (CET) Warsaw
Webinarium na żywo
śro. 10 czerwca 2026
8:00 (CET) Warsaw
Nacho Fernández-Baca DDS, MSc
Webinarium na żywo
czw. 11 czerwca 2026
1:00 (CET) Warsaw



 Austria / Österreich
Austria / Österreich
 Bośnia i Hercegowina / Босна и Херцеговина
Bośnia i Hercegowina / Босна и Херцеговина
 Bułgaria / България
Bułgaria / България
 Chorwacja / Hrvatska
Chorwacja / Hrvatska
 Czechy i Słowacja / Česká republika & Slovensko
Czechy i Słowacja / Česká republika & Slovensko
 Francja / France
Francja / France
 Niemcy / Deutschland
Niemcy / Deutschland
 Grecja / ΕΛΛΑΔΑ
Grecja / ΕΛΛΑΔΑ
 Węgry / Hungary
Węgry / Hungary
 Włochy / Italia
Włochy / Italia
 Holandia / Nederland
Holandia / Nederland
 nordycki / Nordic
nordycki / Nordic
 Polska / Polska
Polska / Polska
 Portugalia / Portugal
Portugalia / Portugal
 Rumunia i Mołdawia / România & Moldova
Rumunia i Mołdawia / România & Moldova
 Słowenia / Slovenija
Słowenia / Slovenija
 Serbia i Czarnogóra / Србија и Црна Гора
Serbia i Czarnogóra / Србија и Црна Гора
 Hiszpania / España
Hiszpania / España
 Szwajcaria / Schweiz
Szwajcaria / Schweiz
 indyk / Türkiye
indyk / Türkiye
 Wielka Brytania i Irlandia / UK & Ireland
Wielka Brytania i Irlandia / UK & Ireland
 Międzynarodowy / International
Międzynarodowy / International
 Brazylia / Brasil
Brazylia / Brasil
 Kanada / Canada
Kanada / Canada
 Ameryka Łacińska / Latinoamérica
Ameryka Łacińska / Latinoamérica
 USA / USA
USA / USA
 Chiny / 中国
Chiny / 中国
 Indie / भारत गणराज्य
Indie / भारत गणराज्य
 Pakistan / Pākistān
Pakistan / Pākistān
 Wietnam / Việt Nam
Wietnam / Việt Nam
 ASEAN / ASEAN
ASEAN / ASEAN
 Izrael / מְדִינַת יִשְׂרָאֵל
Izrael / מְדִינַת יִשְׂרָאֵל
 Algieria, Maroko i Tunezja / الجزائر والمغرب وتونس
Algieria, Maroko i Tunezja / الجزائر والمغرب وتونس
 Bliski Wschód / Middle East
Bliski Wschód / Middle East

To post a reply please login or register